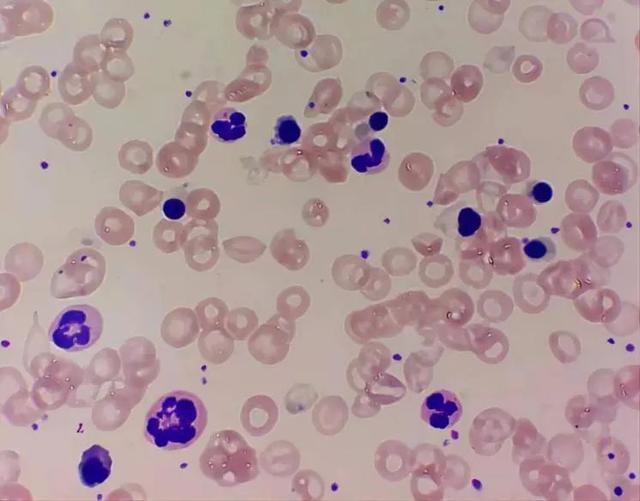

白细胞是机体的一种正常的免疫系统的一个细胞,当机体受到细菌、病毒等外来病原体的入侵时产生白细胞升高的一种自我保护机制,同时在使用某些药物(糖皮质激素等)的过程中也会引起白细胞等细胞的升高。
生理性白细胞增高多见于剧烈运动、进食后、妊娠、新生儿。另外采血部位不同,也可使白细胞数有差异,如耳垂血比手指血的白细胞数平均要高一些。

病理性白细胞增高:
(1)某些细菌性感染所引发的疾病,特别是化脓性球菌引起的局部炎症和全身性感染,如:脓肿、化脓性脑膜炎、肺炎、阑尾炎、中耳炎、扁桃体炎、脓胸、肾盂炎、输卵管炎、胆囊炎及败血症等。
(2)某些病毒性感染所导致的疾病:乙型脑炎,传染性单核细胞增多症,麻疹等。
(3)严重的组织损伤或坏死:如大手术后,烧伤,急性出血严重创伤,血管栓塞等。
(4)过敏反应:如输血反应,药物过敏,急性变态反应性疾病等。
(5)中毒反应:如各种药物中毒,农药中毒,重金属中毒,糖尿病酸中毒,妊娠中毒症等。
(6)肿瘤及血液病:慢性粒细胞白血病,急性粒细胞白血病等。
(7)应用某些升白细胞的化学药物促使白细胞增高,多见于化疗和放疗治疗期间因白细胞数量急剧减少时,需要尽快提升白细胞而进行下一步疗程治疗的患者。
白细胞升高,说明身体有细菌感染,孩子的感染,大多是呼吸道或是消化道的感染居多,检查孩子的呼吸道,如鼻子是否通气,咽喉部是否疼痛,或咳嗽。是否有头痛,消化道方面,看宝宝是否有腹痛,厌食,便秘或腹泻,腹胀等,如果仔细观察,就不难发现问题的所在,发现问题后要多跟医生交流,医生会根据化验单和身体的体征做相应的处理,细菌感染可选用适当的抗菌素治疗,不要紧张,宝宝很快会好的。